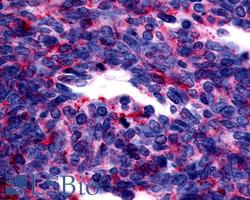
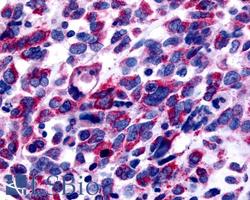

LS-A100463
antibody from LSBio
Targeting: GPER1
CEPR, CMKRL2, DRY12, FEG-1, GPCR-Br, GPER, GPR30, LERGU, LERGU2, LyGPR
Antibody data
- Antibody Data
- Antigen structure
- References [0]
- Comments [0]
- Validations
- Immunohistochemistry [6]
Submit
Validation data
Reference
Comment
Report error
- Product number
- LS-A100463 - Provider product page

- Provider
- LSBio
- Product name
- IHC-plus™ GPER1 / GPR30 Antibody (Cytoplasmic Domain, AP) LS-A100463
- Antibody type
- Polyclonal
- Description
- Immunoaffinity purified
- Reactivity
- Human
- Host
- Rabbit
- Conjugate
- Alkaline Phosphatase
- Storage
- Aliquot and store undiluted at -20°C or below for up to 1 year. Can be stored undiluted at 4°C for up to 1 month. Avoid freeze-thaw cycles.
No comments: Submit comment
Supportive validation
- Submitted by
- LSBio (provider)
- Main image

- Experimental details
- Anti-GPER1 / GPR30 antibody IHC of human breast, carcinoma. Immunohistochemistry of formalin-fixed, paraffin-embedded tissue after heat-induced antigen retrieval.
- Submitted by
- LSBio (provider)
- Main image

- Experimental details
- Anti-GPER1 / GPR30 antibody IHC of human colon, carcinoma. Immunohistochemistry of formalin-fixed, paraffin-embedded tissue after heat-induced antigen retrieval.
- Submitted by
- LSBio (provider)
- Main image
- Experimental details
- Anti-GPER1 / GPR30 antibody IHC of human Lung, Small Cell Carcinoma. Immunohistochemistry of formalin-fixed, paraffin-embedded tissue after heat-induced antigen retrieval.
- Submitted by
- LSBio (provider)
- Main image
- Experimental details
- Anti-GPER1 / GPR30 antibody IHC of human Skin, Melanoma. Immunohistochemistry of formalin-fixed, paraffin-embedded tissue after heat-induced antigen retrieval.
- Submitted by
- LSBio (provider)
- Main image

- Experimental details
- Anti-GPER1 / GPR30 antibody IHC of human adrenal. Immunohistochemistry of formalin-fixed, paraffin-embedded tissue after heat-induced antigen retrieval.
- Submitted by
- LSBio (provider)
- Main image

- Experimental details
- Human, Pancreas, Islet: Formalin-Fixed Paraffin-Embedded (FFPE)
 Explore
Explore Validate
Validate Learn
Learn Western blot
Western blot Immunohistochemistry
Immunohistochemistry